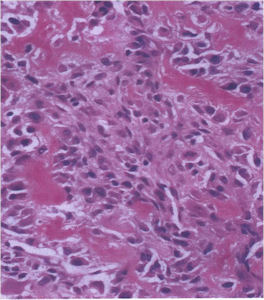

General Information
- Benign osteoblastic neoplasm with aggressive growth pattern (considered a benign aggressive tumor)
- Histologically it is similar to osteoid osteoma but is a larger size and grows progressively
- Consists of well vascularized connective tissue stroma with interconnecting trabeculae of osteoid and woven bone
- Osteoblastomas are rare tumors and constitute about 1% of excised primary bone tumors
- Osteosarcoma is 20x more common and osteoid osteoma is 4x more common than osteoblastoma
- There is a more aggressive form of osteoblastoma in which recurrences are more common. These tumors have a higher chance of coming back after they are removed.
Clinical Presentation
Signs/Symptoms:
- Pain is the most common presenting symptom
- Pain is usually less severe and less pronounced at night and may or may not be relieved by aspirin compared to an osteoid osteoma in which night pain is particularly severe and the pain is usually reliable relieved with an aspirin or NSAID
- Spinal lesions may be accompanied by muscle spasms, scoliosis and neurological manifestations
Prevalence:
- Males: Females 2-3:1
Age:
- Patients are young, Median age 18
- 80% of patients are between 10 and 30 years old
Sites:
- Spine (40% of cases; usually posterior elements)
- Long Bones (30%; Most arise from diaphysis or metaphysis; Epiphyseal lesions are rare but may occur more often in the tubular bones of the hands or feet)
Radiographic Presentation
Plain X-rays:
- Geographic, circumscribed lesion usually around 5cm in size.
- There may be expansion of bone, cortical thinning and cortical breakthrough. A soft tissue mass may accompany this lesion but the soft tissue component is usually contained by the periosteum.
- The periosteum remains intact around the soft tissue component. Might need a CT scan to detect the subtle calcification (Egg Shell Rim of Calcification) associated with an intact periosteal reaction
- The lesion may be entirely radiolucent but usually shows some degree of mineralization. Mineralization may appear stippled like cartilage but do not see chondroid pathologically. Mineralization is sometimes better detected on a CT scan rather than an x-ray.
- Usually less surrounding sclerosis than an osteoid osteoma.
- Arise from the Diaphysis (75%) more commonly than Metaphyseal (25%)
- 4 cm to 6 cm in size
Bone Scan:
- Increased uptake at the site of the lesion
CT Scan:
- More useful for detecting mineralization and evaluating extent of bone destruction than plain X-ray
MRI:
- Also useful in determining extent
- There is often extensive edema around the tumor in the surrounding bone and soft tissues that can lead to a misdiagnosis of a malignant tumor.
























Osteoblastoma
Differential between Osteoid Osteoma and Osteoblastoma
- Osteoblastoma
- Size: >1.5-2cm
- Growth: Benign Aggressive Lesion: Continues to grow and destroy bone (osteoid osteoma has a limited growth potential–indolent)
- Soft Tissue Mass with an Osteoblastoma
- Scoliosis and classical symptoms absent with Osteoblastoma
- Matrix is multifocal in an osteoblastoma and not central
Gross Pathology
The gross pathology of an osteoblastoma is indistinguishable from an osteoid osteoma except larger
- Nidus is well demarcated
- Granular, friable, reddish hemorrhagic tissue
- May bleed significantly when curetted
- Cortex is thinned, possibly destroyed
Microscopic Pathology
- Interlacing network of bone trabeculae in a loose fibrovascular stroma
- Prominent vessels
- Osteoblasts are plump, active, scattered mitotic figures
- Osteoblasts line up around periphery of trabeculae (Osteoblastic Rimming)
- Soft tissue component usually surrounded by shell of reactive bone or periosteum (Egg Shell Rim of Calcification)
- No cartilage production (as opposed to osteosarcomas that may contain areas of cartilage)











Aggressive Osteoblastoma
- Aggressive osteoblastoma is a distinct rare type of osteoblastoma that has a much more aggressive local behavior than a conventional osteoblastoma. They have a higher chance for local recurrence after removal.
- There has been controversy about the true existence of this type of tumor and whether these tumors are actually low grade osteosarcomas.
- They have a similar appearance microscopically as a conventional osteoblastoma except the osteoblasts are twice as large and have an epithelioid quality with abundant eosinophilic cytoplasm (Epithelioid Osteoblasts).
- Aggressive osteoblastoma is a borderline lesion lesion between osteoblastoma and osteosarcoma. It is not a precursor to osteosarcoma. It does not metastasize.
- Aggressive osteoblastomas usually occur in an older age group than conventional osteoblastoma.
- Most patients are older than age 30. It affects a broad variety of bones.
- Aggressive osteoblastomas are usually larger than a conventional osteoblastoma and have been reported to be up to 8.5 cm in diameter.
- Most have a similar radiographic appearance as a conventional osteoblastoma and have well defined margins, variable amounts of mineralization and peritumoral sclerosis. They occasionally have radiographic characteristics consistent with malignancy.
- Aggressive osteoblastomas are locally aggressive but never metastasize.

Aggressive Osteoblastoma
Differential Diagnosis:
- Osteoid Osteoma
- Conventional Osteoblastoma
- Osteosarcoma
The differential between osteoid osteoma, conventional osteoblastoma and aggressive osteoblastoma is based on size and the presence of epithelioid osteoblasts. Can have epithelioid osteoblasts in osteoid osteoma and conventional osteoblastoma but they do not occur in cohesive sheets that fill intertrabecular spaces
Aggressive Osteoblastoma vs. Osteosarcoma
Osteosarcoma:
- Cellular atypia
- High mitotic rate
- Atypical mitotic figures
- Abundant lacelike osteoid
- Permeative growth into adjacent bone and soft tissue
- Presence of neoplastic cartilage
- No peripheral shell of reactive bone
Pathology:
- Differentiation from osteosarcoma
- Osteoblastomas that are greater than 4 cm and that show prominent periosteal new bone formation may present problems in differentiation from osteosarcoma
- May have foci of lace-like osteoid, high cellularity and more than a few scattered mitotic figures but these characteristics usually occur independently in an osteoblastoma vs all these atypical characteristics being present in an osteosarcoma







Treatment
Extremity Lesions:
- Intralesional Curettage Resection and Cement Fixation vs. Bone Grafting
- Local adjuvant may be considered such as cryosurgery to reduce the risk of local recurrence
- En-bloc excision for massive tumors
Spine lesions:
- En-bloc resection (recurrence may be as high as 25%)
- Radiotherapy may be recommended after inadequate removal
- Rarely—malignant transformation after radiation
Prognosis
- Majority of patients are cured by initial therapy
- Recurrences usually occur within 2 years from initial surgery from regrowth of microscopic cells
- Recurrences after 2 years is very rare
- Recurrences in spine are more common and occur in approximately 25% of cases